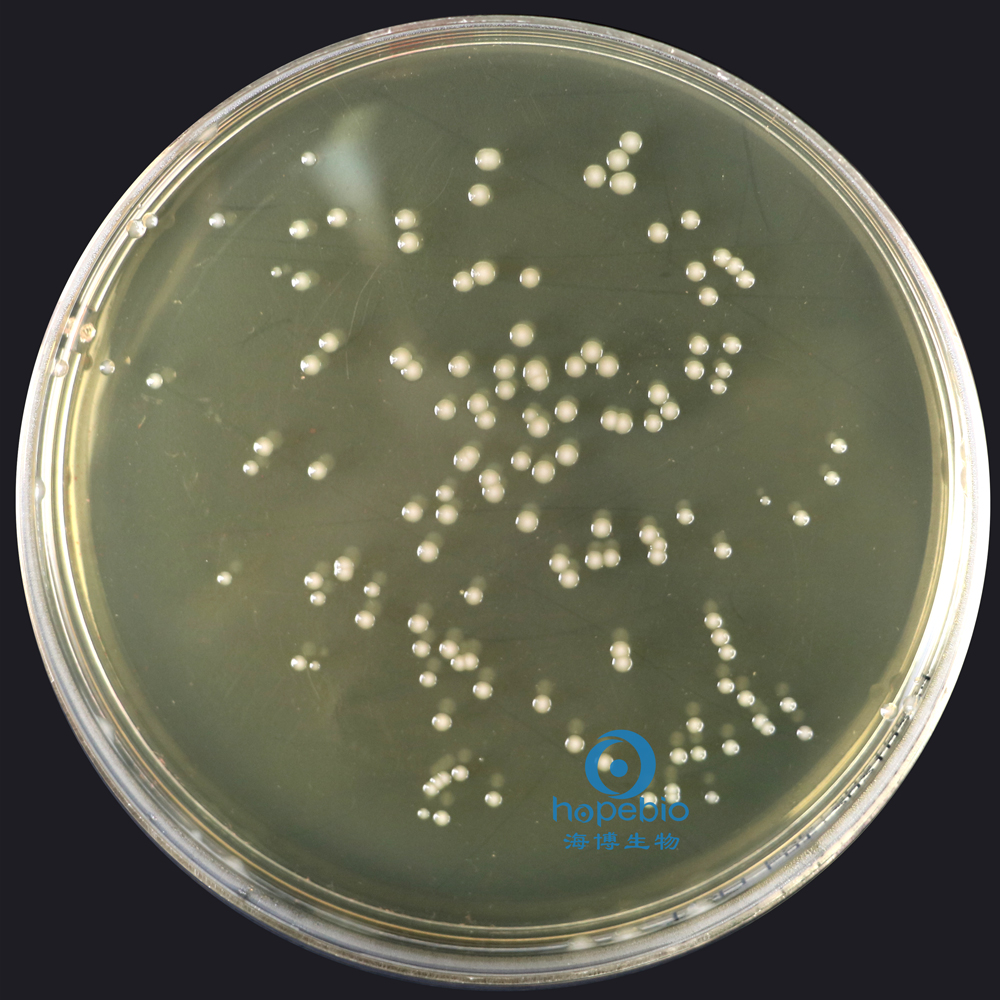
铜绿假单胞菌  有绿色色素

相关产品推荐更多 >
万千商家帮你免费找货
0 人在求购买到急需产品
- 详细信息
- 文献和实验
- 技术资料
- 库存:
999
- 英文名:
TSA Agar
- 保质期:
三年
- 供应商:
青岛海博生物
- 规格:
9cm*10
参比培养基:依据培养基配方特别制备,质量优良的培养基,用于培养基的质量控制,以保证食品微生物检验用培养基的质量。参比培养基需由具备相应检验能力,并取得通过国家认证认可资质检验机构出具的检测报告。海博生物参比培养基系列产品的配方及质量控制均符合GB4789.28-2024标准要求,并可出具CNAS报告,请放心使用。
用途:一种通用的营养培养基,用于各种微生物的培养。
包装方式:一次性无菌塑料平皿 9cm 辐照灭菌
检验原理:
胰蛋白胨、大豆胨提供氮源、维生素和生长因子;氯化钠维持均衡的渗透压;琼脂是培养基的凝固剂。
不同细菌在胰蛋白胨大豆琼脂(TSA)上的生长特征:
![]() | ![]() | |||
|
金黄SE葡萄球菌 有黄色色素 |
大肠埃希氏菌 无色透明大菌落 | |||
![]() | ![]() | |||
|
鼠伤寒SHA门氏菌 无色大菌落 |
铜绿假单胞菌 有绿色色素 | |||
![]() | ![]() | |||
|
枯草芽孢杆菌 白色不规则菌落 |
白色念珠菌 白色菌落 | |||
![]() | ||||
|
黑QU霉 白色菌丝 | ||||
胰蛋白胨大豆琼脂(TSA)平板(9cm)(参比培养基)微生物灵敏度试验:
按标签用法制备培养基,接种以下质控菌株,放置36℃需氧培养24±2小时。

风险提示:丁香通仅作为第三方平台,为商家信息发布提供平台空间。用户咨询产品时请注意保护个人信息及财产安全,合理判断,谨慎选购商品,商家和用户对交易行为负责。对于医疗器械类产品,请先查证核实企业经营资质和医疗器械产品注册证情况。
文献和实验实验试剂 1. SOC培养基(将20g细菌培养用胰蛋白胨、5g酵母提取物及0.5g NaCl溶于950ml水中。加入10m1 250mmol/L KCl,5mol/L NaOH调整pH至7.0并加入去离子水至IL。高压灭菌。手感变凉后,再加入5ml 2mol/L MgCl2 和20ml lmol/L葡萄糖) 2. 100mm和150mm含100ug/m1氨苄青霉素和2%葡萄糖的TYE平板(TYE/amp/glu)(将16g细菌培养用胰蛋白胨、10g酵母提取物、5g
原理将样品经增菌后划平板分离单菌落,挑取可疑菌落到胰蛋白胨葡萄糖酵母浸膏肉汤 (TPGY)培养基培养,对培养物用 DNA 提取试剂盒抽提 DNA,进行 PCR 扩增,用琼脂糖凝胶电泳检验 PCR 产物中是否含有肉毒杆菌的的特征条带,从而初步判断食品是否被肉毒杆菌污染。 二、仪器和试剂 紫外检测仪 NanoDrop1000 (Eppendorf),台式微量冷冻离心机 Microfuge 22R(Beckman Counter),凝胶成像分析系统 Gel DocTM XR (Bio
(滤纸培养基) (NH4)2SO4 1g KH2PO4 1g MgSO4.7H2O 0.7g NaCl 0.5g Distilled water (蒸馏水) 1000ml A strip of filter paper (滤纸条) 6ⅹ1cm (厘米)20、Soybean Cake Meal Agar (黄豆饼粉琼脂) 10% infusion of soybean cake meal (10%黄豆饼粉浸汁) 1000ml Glucose (葡萄糖) 10g NaCl 2.5g21、Sawdust
技术资料暂无技术资料 索取技术资料